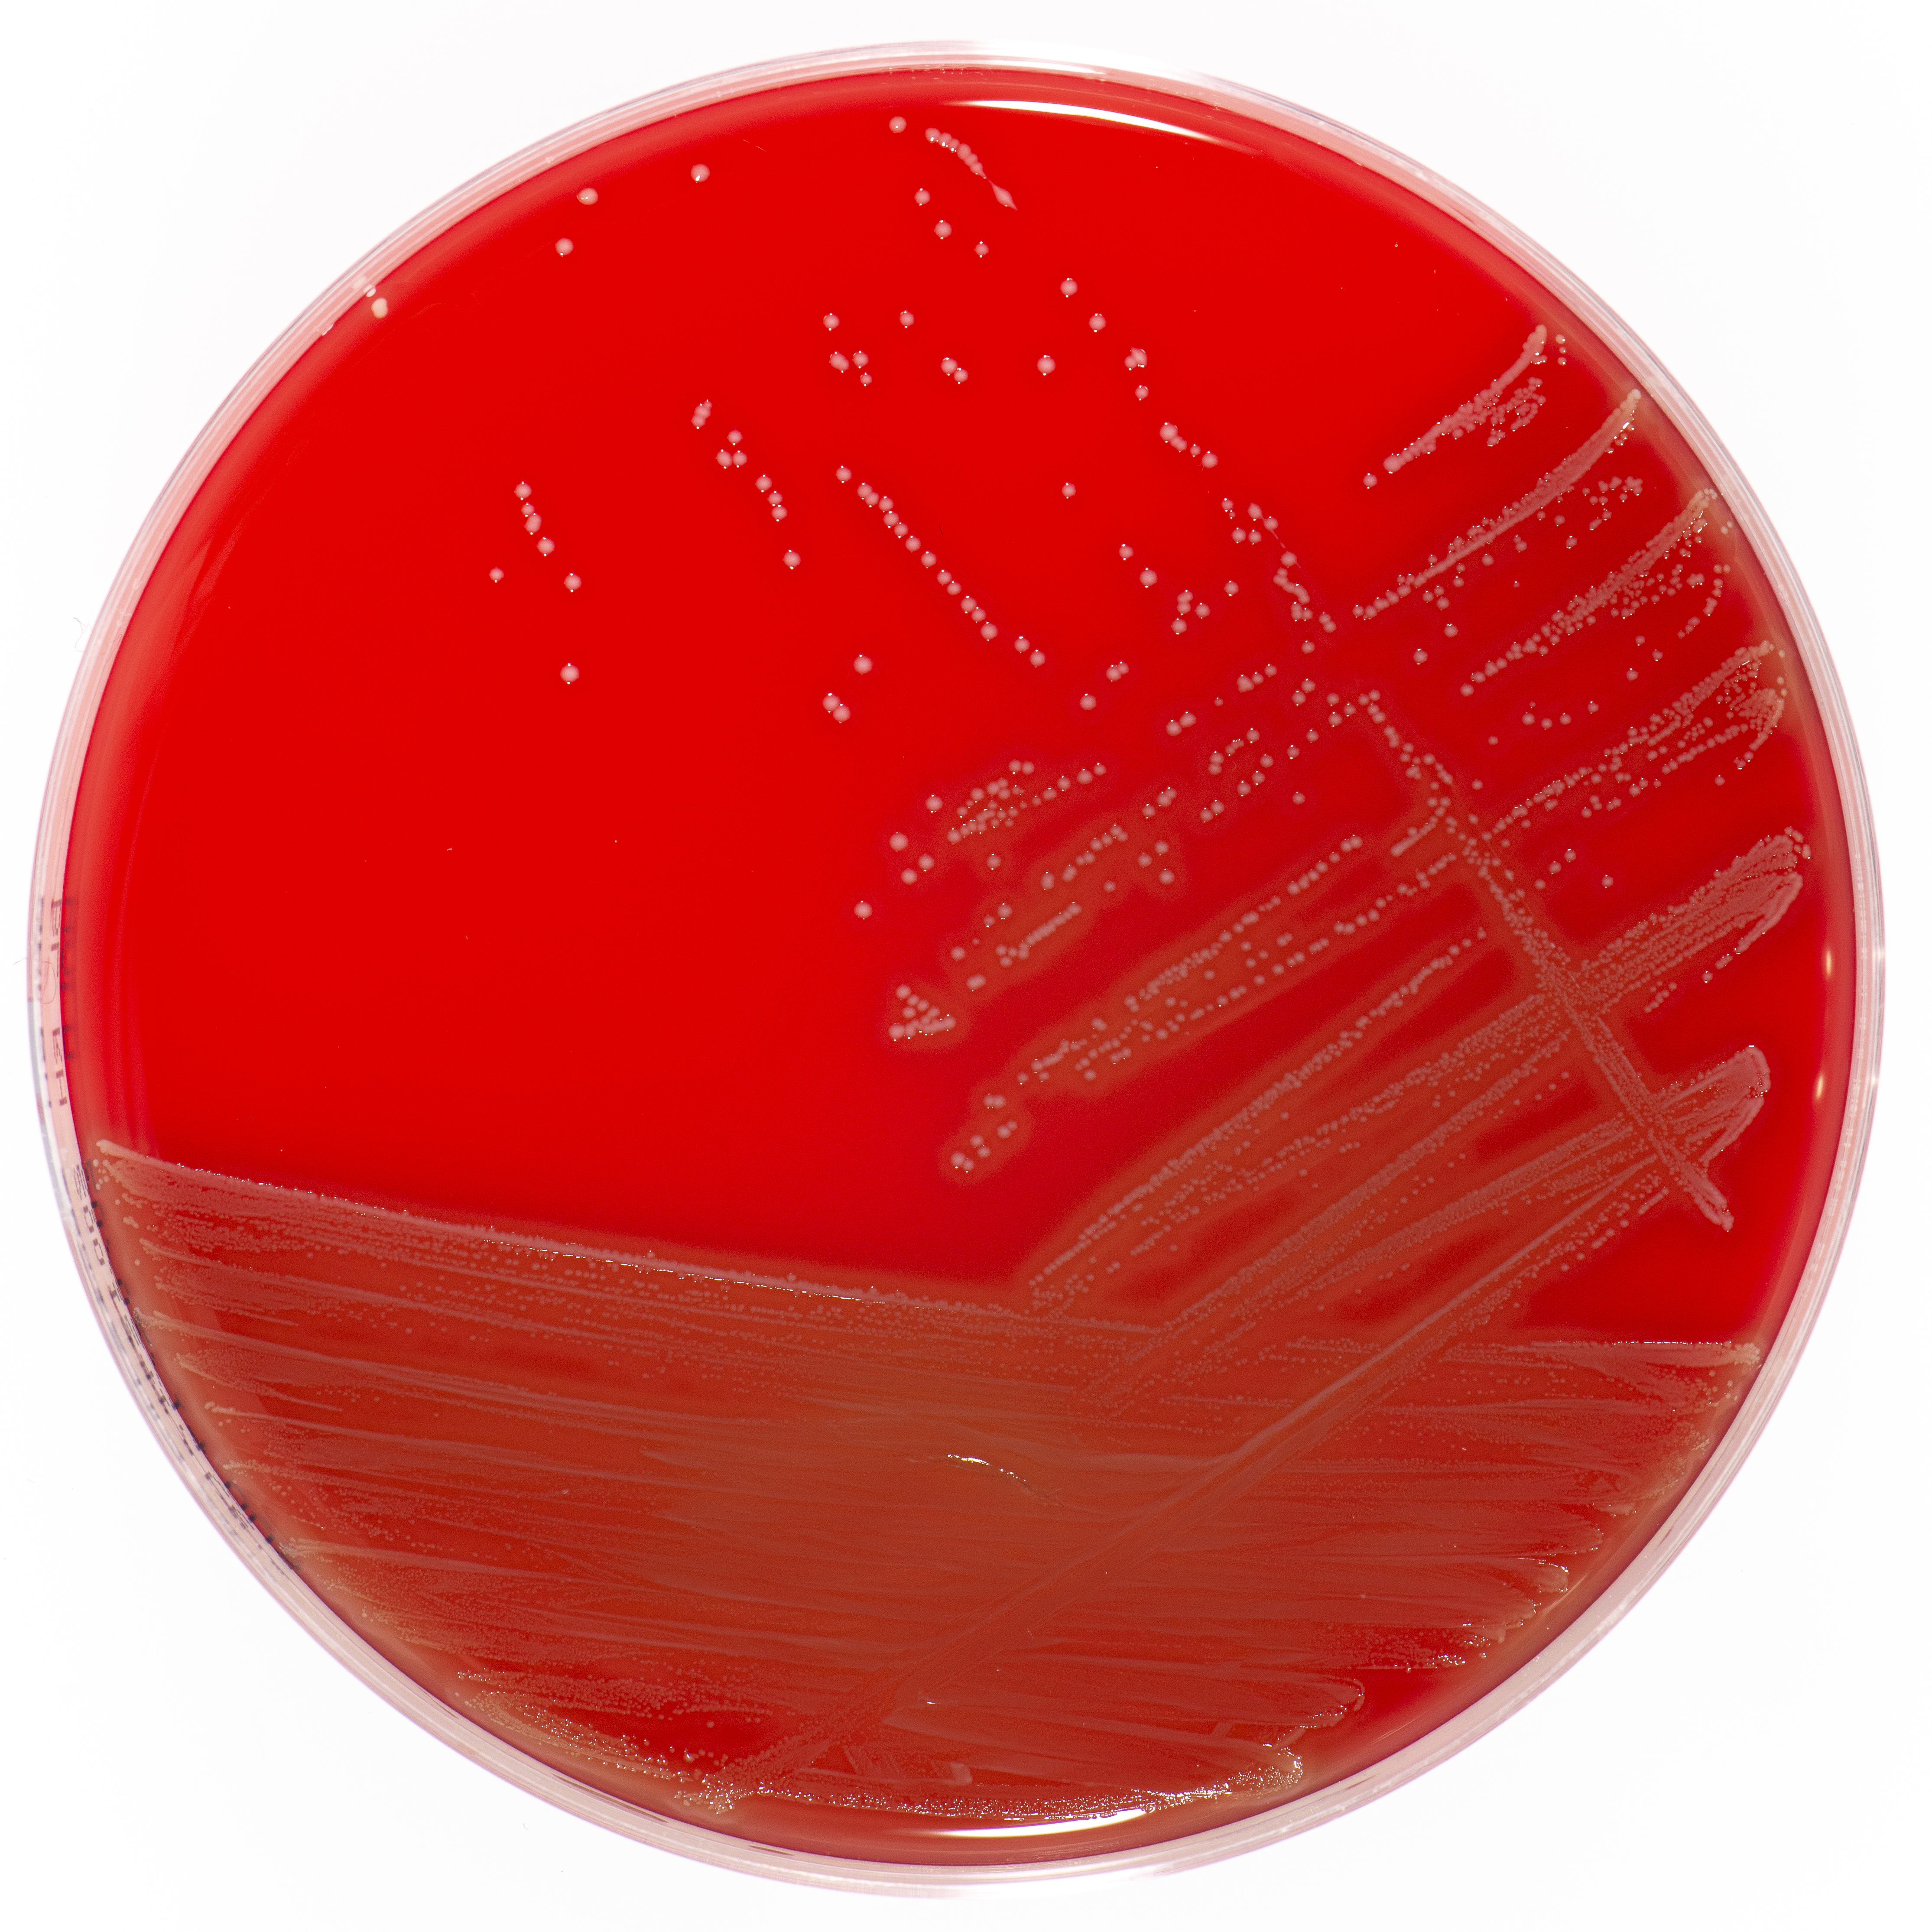
puss-abdomen_blod

| Pasienten er en 65 år gammel pensjonert pilot som under opphold i sin ferieleilighet i Thailand fikk blod i avføringen. Etter hjemkomst til Norge ble han innlagt på kirurgisk avdeling og operert for kreft i tykktarmen. Dagen etter operasjonen fikk han sterke smerter i magen. Ved undersøkelse var abdomen bretthard og slippøm. CT abdomen viste væske og fri luft i buken. Pasienten ble i all hast lagt på operasjonsbordet. I buken ble det funnet brunlig puss. Det ble tatt pussprøve. Etter operasjonen ble han satt på cefotaksim intravenøst. Neste dag fikk pasienten frostanfall og hadde temperatur på 39,2 ºC. Blodkulturer ble tatt. |
Pusset blir sådd ut med enkeltkoloniteknikk på følgende dyrkningsmedier: blodskål, laktoseskål og HMKV (anaerob skål) med metronidazol-antibiotikalapp. Skålene blir inkubert i 37⁰C over natt.

Pusset strykes på et objektglass. Når det har tørket blir preparatet fiksert og farget med Gram- farging. Preparatet mikroskoperes med 100x okular og med oljeimmersjon (>1000 ganger forstørrelse):

Etter åtte timer inkubering varsler blodkulturinstrumentet mulig vekst av bakterier. To dråper blod strykes ut på et objektglass. Når det har tørket blir preparatet fiksert og farget med Gram- farging.
